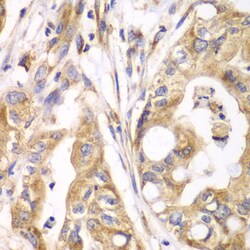
Invitrogen TrxR2 Polyclonal Antibody 100 &mu;L; Unconjugated:Antibodies,

Learn More
Invitrogen™ TrxR2 Polyclonal Antibody


Rabbit Polyclonal Antibody
Brand: Invitrogen™ PA596344
Description
Immunogen sequence: AALLGGLIQD APNYGWEVAQ PVPHDWRKMA EAVQNHVKSL NWGHRVQLQD RKVKYFNIKA SFVDEHTVCG VAKGGKEILL SADHIIIATG GRPRYPTHIE GALEYGITSD DIFWLKESPG KTLVVGASYV ALECAGFLTG IGLDTTIMMR SIPLRGFDQQ MSSMVIEHMA SHGTRFLRGC APSRVRRLPD GQLQVTWEDS TTGKEDTGTF D; Positive Samples: 293T, HepG2, Mouse spleen; Cellular Location: Mitochondrion.
The mammalian thioredoxin reductases (TrxRs) are a family of selenocysteine-containing pyridine nucleotide-disulfide oxidoreductases. All the mammalian TrxRs are homologous to glutathione reductase with respect to primary structure including the conserved redox catalytic site (-Cys-Val-Asn-Val-Gly-Cys-) but distinctively with a C-terminal extension containing a catalytically active penultimate selenocysteine (SeCys) residue in the conserved sequence (-Gly-Cys-SeCys-Gly). TrxR is homodimeric protein in which each monomer includes an FAD prosthetic group, a NADPH binding site and a redox catalytic site. Electrons are transferred from NADPH via FAD and the active-site disulfide to C-terminal SeCys-containing redox center, which then reduces the substrate like thioredoxin. The members of TrxR family are 55-58 kilodalton in molecular size and composed of three isoforms including cytosolic TrxR1, mitochondrial TrxR2, and TrxR3, known as Trx and GSSG reductase (TGR). TrxR plays a key role in protection of cells against oxidative stress and redox-regulatory mechanism of transcription factors and various biological phenomena.
Specifications
| TrxR2 | |
| Polyclonal | |
| Unconjugated | |
| TXNRD2 | |
| AA118373; ESTM573010; KIAA1652; Selenoprotein Z; SelZ; TGR; thioredoxin reductase 2; thioredoxin reductase 2, mitochondrial; thioredoxin reductase 3; thioredoxin reductase beta; thioredoxin reductase TR3; TR; TR beta; TR3; TR-BETA; Trxr2; Trxrd2; TXNRD2 | |
| Rabbit | |
| Affinity Chromatography | |
| RUO | |
| 10587, 26462 | |
| -20°C, Avoid Freeze/Thaw Cycles | |
| Liquid |
| ELISA, Immunohistochemistry (Paraffin), Western Blot, Immunocytochemistry | |
| 0.79 mg/mL | |
| PBS with 50% glycerol and 0.02% sodium azide; pH 7.3 | |
| Q9JLT4, Q9NNW7 | |
| TXNRD2 | |
| Recombinant fusion protein containing a sequence corresponding to amino acids 100-310 of human Thioredoxin reductase 2 (Thioredoxin reductase 2 (TXNRD2 ) ) (NP_0064312). | |
| 100 μL | |
| Primary | |
| Human, Mouse | |
| Antibody | |
| IgG |
Your input is important to us. Please complete this form to provide feedback related to the content on this product.